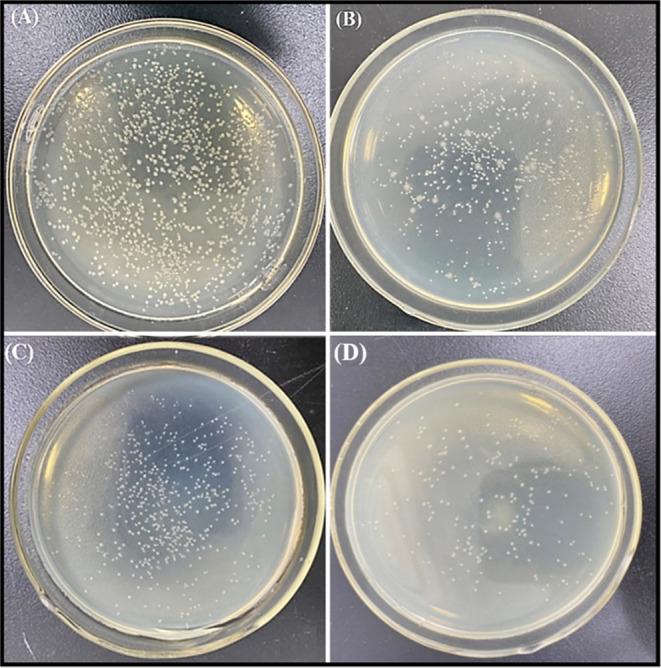
https://cdn.ncbi.nlm.nih.gov/pmc/blobs/1487/10753725/236aedc436bd/ao3c07606_0010.jpg

基于金属有机框架的ZIF-8@ZIF-67纳米复合材料的合成及其抗生素分解和抗菌活性
Synthesis of Metal-Organic Framework-Based ZIF-8@ZIF-67 Nanocomposites for Antibiotic Decomposition and Antibacterial Activities.
作者信息
Sadiq Samreen, Khan Iltaf, Humayun Muhammad, Wu Ping, Khan Abbas, Khan Sohail, Khan Aftab, Khan Shoaib, Alanazi Amal Faleh, Bououdina Mohamed
机构信息
School of Biotechnology, Jiangsu University of Science and Technology, Zhenjiang 212100, Jiangsu, China.
School of Environmental and Chemical Engineering, Jiangsu University of Science and Technology, Zhenjiang 212100, China.
出版信息
ACS Omega. 2023 Dec 12;8(51):49244-49258. doi: 10.1021/acsomega.3c07606. eCollection 2023 Dec 26.
Toxic antibiotic effluents and antibiotic-resistant bacteria constitute a threat to global health. So, scientists are investigating high-performance materials for antibiotic decomposition and antibacterial activities. In this novel research work, we have successfully designed ZIF-8@ZIF-67 nanocomposites via sol-gel and solvothermal approaches. The ZIF-8@ZIF-67 nanocomposite is characterized by various techniques that exhibit superior surface area enhancement, charge separation, and high light absorption performance. Yet, ZIF-8 has high adsorption rates and active sites, while ZIF-67 has larger pore volume and efficient adsorption and reaction capabilities, demonstrating that the ZIF-8@ZIF-67 nanocomposite outperforms pristine ZIF-8 and ZIF-67. Compared with pristine ZIF-8 and ZIF-67, the most active 6ZIF-67@ZIF-8 nanocomposite showed higher decomposition efficacy for ciprofloxacin (65%), levofloxacin (54%), and ofloxacin (48%). Scavenger experiments confirmed that OH, O, and h are the most active species for the decomposition of ciprofloxacin (CIP), levofloxacin (LF), and ofloxacin (OFX), respectively. In addition, the 6ZIF-67/ZIF-8 nanocomposite suggested its potential applications in for growth inhibition zone, antibacterial activity, and decreased viability. Moreover, the stability test and decomposition pathway of CIP, LF, and OFX were also proposed. Finally, our study aims to enhance the efficiency and stability of ZIF-8@ZIF-67 nanocomposite and potentially enable its applications in antibiotic decomposition, antibacterial activities, and environmental remediation.
有毒抗生素废水和抗生素抗性细菌对全球健康构成威胁。因此,科学家们正在研究用于抗生素分解和抗菌活性的高性能材料。在这项新颖的研究工作中,我们通过溶胶 - 凝胶法和溶剂热法成功设计了ZIF - 8@ZIF - 67纳米复合材料。ZIF - 8@ZIF - 67纳米复合材料通过各种技术进行了表征,这些技术显示出优异的表面积增强、电荷分离和高光吸收性能。然而,ZIF - 8具有高吸附率和活性位点,而ZIF - 67具有更大的孔体积以及高效的吸附和反应能力,这表明ZIF - 8@ZIF - 67纳米复合材料优于原始的ZIF - 8和ZIF - 67。与原始的ZIF - 8和ZIF - 67相比,活性最高的6ZIF - 67@ZIF - 8纳米复合材料对环丙沙星(65%)、左氧氟沙星(54%)和氧氟沙星(48%)表现出更高的分解效率。清除剂实验证实,OH、O和h分别是环丙沙星(CIP)、左氧氟沙星(LF)和氧氟沙星(OFX)分解的最活跃物种。此外,6ZIF - 67/ZIF - 8纳米复合材料在生长抑制区、抗菌活性和降低生存能力方面显示出潜在应用。此外,还提出了CIP、LF和OFX的稳定性测试和分解途径。最后,我们的研究旨在提高ZIF - 8@ZIF - 67纳米复合材料的效率和稳定性,并有可能使其应用于抗生素分解、抗菌活性和环境修复。